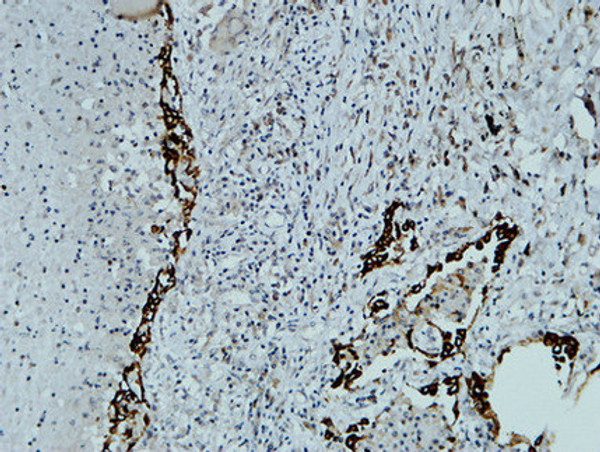
Immunohistochemical analysis of paraffin-embedded Human lung. 1, Antibody was diluted at 1:200 (4°C overnight). 2, High-pressure and temperature EDTA, pH8.0 was used for antigen retrieval. 3, Secondary antibody was diluted at 1:200 (room temperature, 30min).

Anti-CAV1 antibody (129-178 aa) (STJ92051)
SPECIFICATIONS
ClonalityPolyclonal
HostRabbit
ConjugationUnconjugated
IsotypeIgG
ImmunogenThe antiserum was produced against synthesized peptide derived from the human Caveolin-1 at the amino acid range 129-178
General Information
| Short Description | Rabbit polyclonal anti-Caveolin-1 (129-178 aa) for use in WB, IHC, IF and ELISA in Human, Mouse and Rat samples. Datasheet included with dilution recommendations, and related reagents. |
| Applications | WB/IHC/IF/ELISA |
| Host | Rabbit |
| Reactivity | Human/Mouse/Rat |
| Note | STRICTLY FOR FURTHER SCIENTIFIC RESEARCH USE ONLY (RUO). MUST NOT TO BE USED IN DIAGNOSTIC OR THERAPEUTIC APPLICATIONS. |
Product Properties
| Clonality | Polyclonal |
| Isotype | IgG |
| Conjugation | Unconjugated |
| Concentration | 1 mg/mL |
| Purification | The antibody was affinity-purified from rabbit antiserum by affinity-chromatography using epitope-specific immunogen. |
| Dilution Range | WB 1:500-2000IF 1:50-300IHC 1:50-300 |
| Formulation | Liquid in PBS containing 50% Glycerol, 0.5% BSA and 0.02% Sodium Azide. |
| Storage Instruction | Store at-20°C for up to 1 year from the date of receipt, and avoid repeat freeze-thaw cycles. |
Target Information
| Gene Symbol | CAV1 |
| Gene ID | 857 |
| Uniprot ID | CAV1_HUMAN |
| Immunogen | The antiserum was produced against synthesized peptide derived from the human Caveolin-1 at the amino acid range 129-178 |
| Immunogen Region | 129-178 aa |
| Specificity | Caveolin-1 Polyclonal Antibody detects endogenous levels of Caveolin-1 protein. |
Additional Info
| Post Translational Modifications | Ubiquitinated. Undergo monoubiquitination and multi- and/or polyubiquitination. Monoubiquitination of N-terminal lysines promotes integration in a ternary complex with UBXN6 and VCP which promotes oligomeric CAV1 targeting to lysosomes for degradation. Ubiquitinated by ZNRF1.leading to degradation and modulation of the TLR4-mediated immune response. The initiator methionine for isoform 2 is removed during or just after translation. The new N-terminal amino acid is then N-acetylated. Phosphorylated at Tyr-14 by ABL1 in response to oxidative stress. |
| Function | May act as a scaffolding protein within caveolar membranes. Forms a stable heterooligomeric complex with CAV2 that targets to lipid rafts and drives caveolae formation. Mediates the recruitment of CAVIN proteins (CAVIN1/2/3/4) to the caveolae. Interacts directly with G-protein alpha subunits and can functionally regulate their activity. Involved in the costimulatory signal essential for T-cell receptor (TCR)-mediated T-cell activation. Its binding to DPP4 induces T-cell proliferation and NF-kappa-B activation in a T-cell receptor/CD3-dependent manner. Recruits CTNNB1 to caveolar membranes and may regulate CTNNB1-mediated signaling through the Wnt pathway. Negatively regulates TGFB1-mediated activation of SMAD2/3 by mediating the internalization of TGFBR1 from membrane rafts leading to its subsequent degradation. Binds 20(S)-hydroxycholesterol (20(S)-OHC). |
| Protein Name | Caveolin-1 |
| Database Links | Reactome: R-HSA-163560Reactome: R-HSA-203615Reactome: R-HSA-203641Reactome: R-HSA-210991Reactome: R-HSA-4641262Reactome: R-HSA-5218920Reactome: R-HSA-8980692Reactome: R-HSA-9009391Reactome: R-HSA-9013026Reactome: R-HSA-9013106Reactome: R-HSA-9013148Reactome: R-HSA-9013149Reactome: R-HSA-9013404Reactome: R-HSA-9013405Reactome: R-HSA-9013406Reactome: R-HSA-9013407Reactome: R-HSA-9013408Reactome: R-HSA-9013409Reactome: R-HSA-9013423Reactome: R-HSA-9035034Reactome: R-HSA-9617828Reactome: R-HSA-9696264Reactome: R-HSA-9696270Reactome: R-HSA-9696273Reactome: R-HSA-9735871Reactome: R-HSA-9755779 |
| Cellular Localisation | Golgi Apparatus MembranePeripheral Membrane ProteinCell MembraneMembraneCaveolaMembrane RaftGolgi ApparatusTrans-Golgi NetworkColocalized With Dpp4 In Membrane RaftsPotential Hairpin-Like Structure In The MembraneMembrane Protein Of Caveolae |
| Alternative Antibody Names | Anti-Caveolin-1 antibodyAnti-CAV1 antibodyAnti-CAV antibody |
Information sourced from Uniprot.org